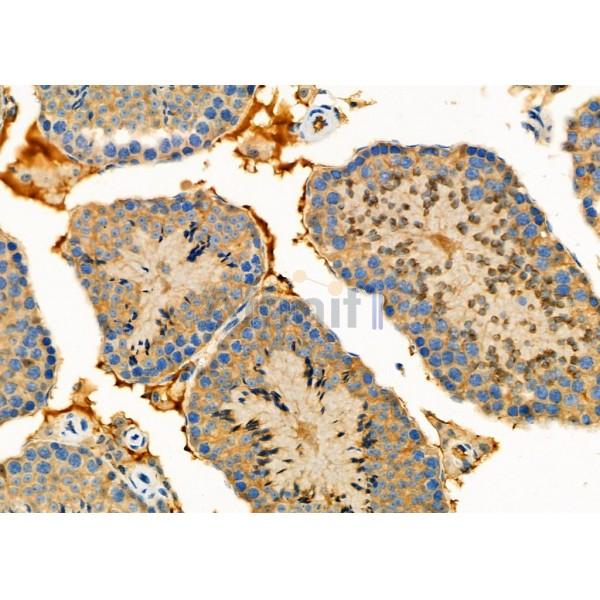
Валидация Affinity DF10007 - 5444

| Каталожный номер |
DF10007 |
| Название антигена |
Versican (VS) |
| UNIPROT |
P13611 |
| Иммуноген |
Синтетический пептид, соответствующий human VCAN на С-конце |
| Английские синонимы |
CSPG2, VCAN, ERVR, PG-M, WGN1, Chondroitin Sulfate Proteoglycan 2, Chondroitin sulfate proteoglycan core protein 2, Glial hyaluronate-binding, Large fibroblast proteoglycan |
Реактивность подтвержденная Нужна другая реактивность? |
человек |
| Реактивность предсказываемая |
корова, овца, кролик, собака, курица, лягушка |
| Источник (хозяин) |
кролик |
| Изотип |
IgG |
| Клональность |
поликлональное |
| Рекомбинантное |
нет |
| Готовое к использованию |
нет |
| Концентрация |
1 мг/мл |
| Конъюгат |
нет |
| Валидировано для |
Иммуногистохимия; Вестерн-блоттинг |
| Рекомендуемые разведения |
WB: 1:1000-3000; IHC: 1:50-1:200; Оптимальное разведение определяется конечным потребителем |
| Метод очистки |
Антисыворотку очищали методом аффинной хроматографии пептидов с использованием связывающей смолы SulfoLink® (Thermo Fisher Scientific) |
| Состав буфера |
Rabbit IgG в PBS; pH 7.4; 150mM NaCl; 0.02% азид натрия и 50% глицерин |
| RRID |
AB_2840587 |
| Условия доставки |
Термобокс с аккумуляторами холода |
| Условия хранения |
Хранить при -20ºС. Стабилен 12 месяцев с даты получения |
| Срок хранения |
12 месяцев |
| Производитель |
Affinity |
| Ссылка на страницу товара на сайте производителя |
https://www.affbiotech.com/goods-10849-DF10007-VCAN_Antibody.html |